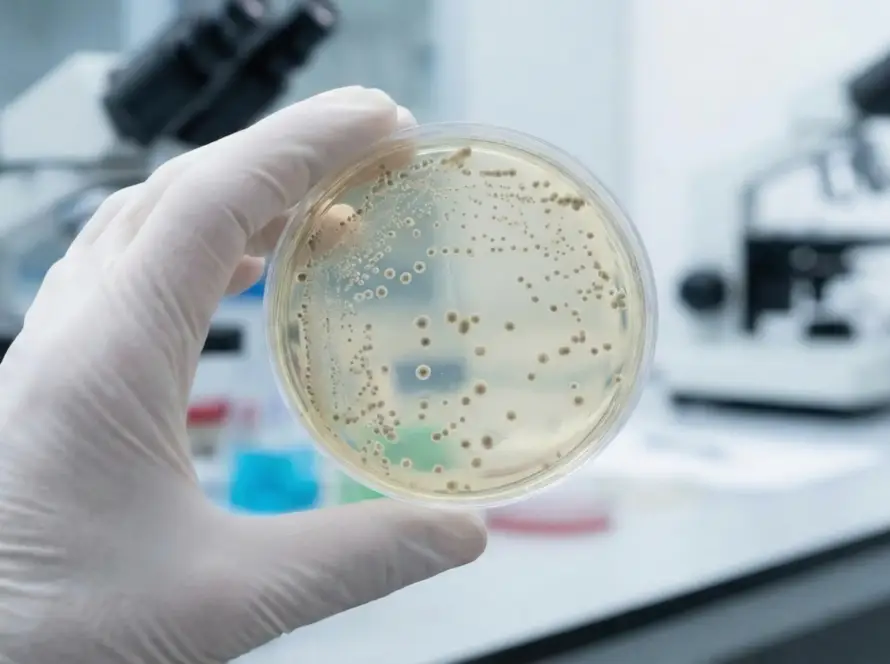

Who We Are
About TerraPHA
Terrapha is a modern biotechnology company redefining sustainability through next-generation innovations. Our portfolio combines advanced biology with clean technology to deliver precision nutrition, intelligent release systems, and environmentally elegant performance across agriculture, aquaculture, and environmental management. At Terrapha, we transform renewable resources into sophisticated, future-ready biomaterials—enabling industries to advance with purpose, efficiency, and a lighter ecological footprint.
Biotech Insights
Technology Features
Planet First
UN-Aligned Sustainability Goals
No Poverty
Terrapha helps create stable jobs across the supply chain from production to distribution. By supporting local employment and reducing dependency on imported materials, we contribute to stronger, more resilient communities.
Good Health & Well-Being
Cleaner, safer feed options help reduce antibiotic use and support better overall animal health. This leads to healthier food systems and lowers the risks associated with antibiotic resistance.
Zero Hunger
Our biopolymer-based feed supplements support healthier aquaculture and livestock systems. By improving efficiency and yield, we help strengthen food production and support growing nutritional needs.
Clean Water & Sanitation
With zero antibiotic residue and cleaner processing, our materials help maintain healthier farm ecosystems. TerraPURO-NP also plays a role in water purification, supporting safer water systems.
Industry, Innovation & Infrastructure
Terrapha supports an innovation-driven ecosystem by improving feed performance and enabling modern, efficient production. This drives more sustainable, technology-led growth across the sector.
Decent Work & Economic Growth
Better-quality feed and efficient production create opportunities for value-added exports and stronger rural economies. As the industry grows, so do income opportunities for farmers and workers.
Climate Action
PHA-based components help improve soil health and carbon content when used in litter and composting systems. This supports better carbon cycling and reduces the overall climate impact of waste.
Affordable & Clean Energy
By converting waste into valuable bio-based inputs, Terrapha lowers the need for energy-heavy raw materials. This supports cleaner production pathways and encourages more efficient, sustainable energy use across the value chain.
Life Below Water
Our fully biodegradable materials reduce plastic pollution risks in water bodies and leave no harmful residues. This helps protect aquatic ecosystems and the species that depend on them.
Sustainable Cities & Communities
Our waste-to-value approach helps reduce environmental pressure on cities and supports cleaner local industries. By converting waste streams into usable products, we help create greener industrial clusters.
Responsible Consumption & Production
We transform organic and industrial wastes into high-value feed materials, reducing reliance on chemical additives. This promotes more responsible, circular production practices across the supply chain.
Life on Land
Our solutions avoid the need for additional farmland and prevent deforestation. With no direct land use pressure, we help preserve natural ecosystems and biodiversity.
Collaboration for Growth
At TerraPHA Biotech, we believe the future of sustainable materials lies in intelligent formulation.
Insights